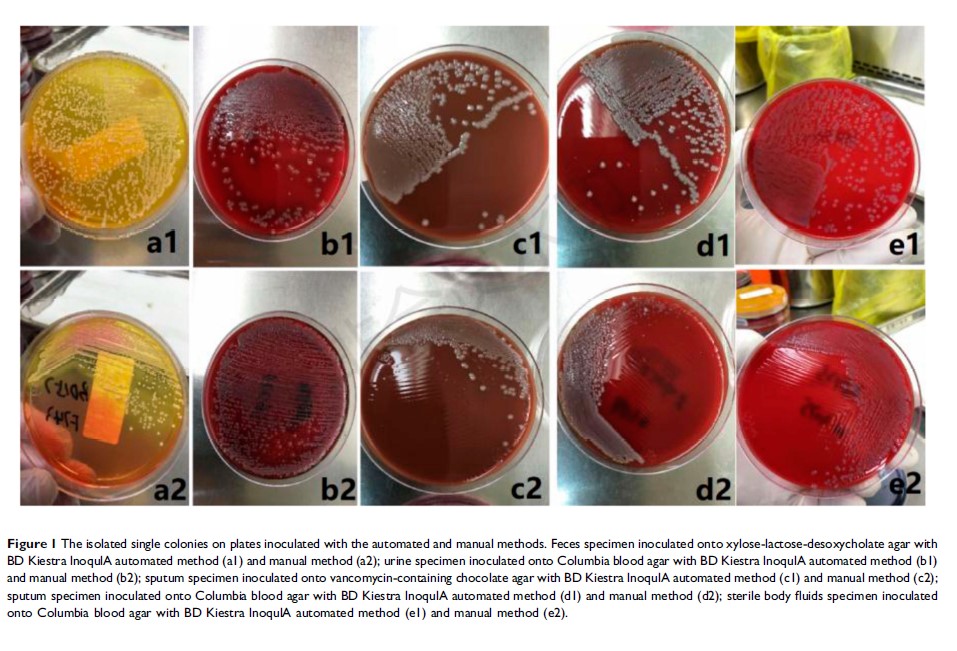

论文已发表
注册即可获取德孚的最新动态
IF 收录期刊
Original Research
LncRNA HOTTIP 通过调节 miR-137 在胰腺癌中的表达参与肿瘤细胞的顺铂耐药性

Original Research
受 lncRNA DSCAM-AS1/miR-122-5p 轴调控的 FSTL3 上调可促进非小细胞肺癌细胞的增殖和迁移

Original Research
BD Kiestra InoqulA 自动化接种系统在中国三甲医院的临床性能评估
Original Research
Egr1 敲除与血管紧张素转换酶(ACE)抑制剂结合可改善小鼠的糖尿病肾病:阻止肾素代偿性增加

Original Research
黄芪多糖可促进阿霉素诱导的胃癌细胞凋亡

Original Research
PCR-反向斑点杂交技术用于人乳头瘤病毒基因分型试验,及对中国患者 CIN 2+ 手术后残留/复发进行评估
